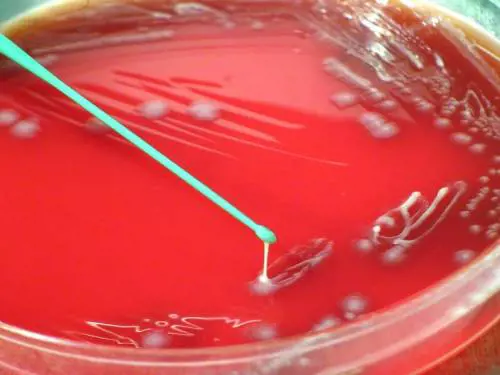
Primo focolaio in Europa della peste dei ruminanti

Cronache
Si tratta del primo focolaio in Europa. Registrato in Bulgaria, al confine con la Turchia. Colpisce ovini, caprini e ruminanti

Si tratta del primo focolaio in Europa. Registrato in Bulgaria, al confine con la Turchia. Colpisce ovini, caprini e ruminanti
In Arizona trovate pulci infette con la peste nera, la malattia che nel XIV secolo falcidiò il 60% della popolazione europea

Dalla peste alla rosolia, tornano le malattie che si credevano scomparse

Il ragazzo pensava di avere l'influenza, poi la corsa in ospedale. A contagiarlo forse una zanzara che aveva punto un topo morto
